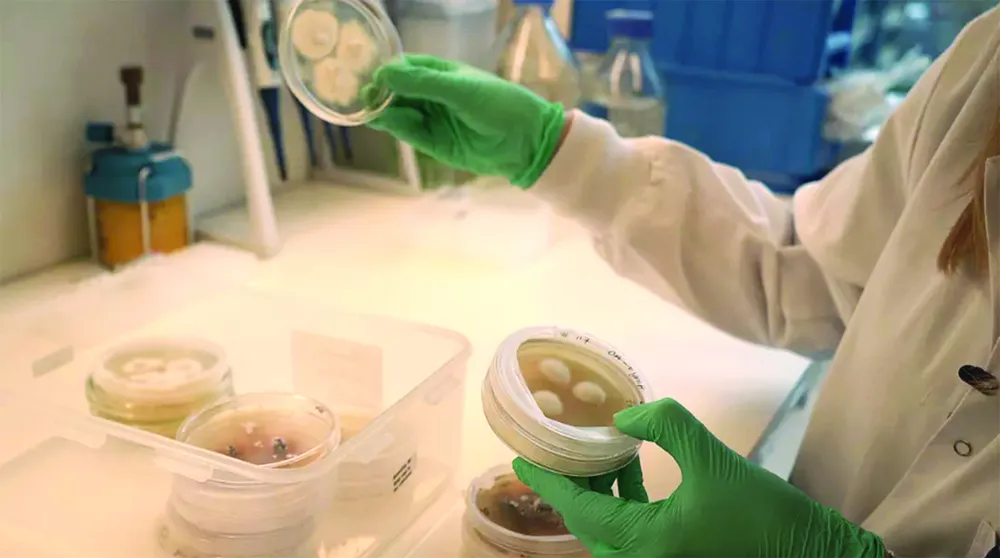
Q8a.jpg

Theo báo cáo từ Viện Thực phẩm tốt cho châu Âu, tổ chức phi lợi nhuận hỗ trợ tài trợ cho dự án, Ủy ban châu Âu đã tài trợ 252 triệu EUR cho nghiên cứu protein thay thế kể từ năm 2020. Báo cáo cũng cho thấy Đan Mạch, Anh, Phần Lan và Hà Lan đang dẫn đầu trong việc tạo ra các loại thực phẩm có nguồn gốc thực vật, thịt nuôi cấy và thực phẩm lên men.
Riêng Đan Mạch nổi bật với số lượng nhà khoa học làm việc trong lĩnh vực này trên đầu người cao nhất, số lượng bài báo nghiên cứu được công bố trên đầu người nhiều nhất và có 3 trong số những tổ chức nghiên cứu protein thay thế hàng đầu châu Âu.
Tiến sĩ Loes van Dam, nhà nghiên cứu tại Đại học Kỹ thuật Đan Mạch, chia sẻ: “Tơ nấm có cấu trúc tương tự như rễ của thực vật, mặc dù nấm thực chất không phải là thực vật”.
Nhóm nghiên cứu đã sử dụng Pleurotus ostreatus, thường được gọi là nấm sò, trong các thí nghiệm của họ. Trong khi nấm của loại nấm này được ăn rộng rãi trên thế giới, thì các đặc tính ẩm thực của cấu trúc rễ của nó phần lớn vẫn chưa được khám phá, các nhà nghiên cứu cho biết. Nấm sợi có thể phát triển trên nhiều loại chất nền khác nhau - ví dụ như bề mặt hữu cơ như đất - điều này ảnh hưởng đến hương vị của chúng.
Theo các nhà nghiên cứu, chúng thậm chí có thể phát triển nhanh chóng trên các vật liệu thải như bã cà phê và gỗ, chứng tỏ tiềm năng như một nguồn protein thay thế bền vững.
Để hiểu rõ hơn về điểm khác biệt của chủng nấm này so với các chủng khác, các nhà nghiên cứu đã sử dụng một phương pháp gọi là giải trình tự bộ gen, cho phép họ kiểm tra “sổ tay hướng dẫn” của nấm hoặc cách nấm phát triển, chuyển hóa chất dinh dưỡng, tạo ra hương vị và kết cấu.
Nhóm nghiên cứu phát hiện ra rằng sợi nấm của nấm sò rất giàu protein và chứa các vi chất dinh dưỡng quan trọng như vitamin B5 và provitamin D2 trong khi mức độ độc tố trong sợi nấm thấp hơn đáng kể so với các quả thể được coi là an toàn để tiêu thụ. Sợi nấm cũng phát triển nhanh hơn nấm thường, rất thích hợp cho sản xuất quy mô công nghiệp.
Trong một cuộc khảo sát trong phòng thí nghiệm, một nhóm 72 người tình nguyện đã có phản ứng tích cực với món nấm sợi trần được nuôi trên nước, nhận thấy có vị umami hoặc hương vị thịt nấu chín. Nhóm nghiên cứu cũng hợp tác với một nhà hàng 2 sao Michelin ở Copenhagen tên là Alchemist để nghiên cứu phản ứng của người tiêu dùng. Các đầu bếp tại Alchemist đã phát triển một món ăn sử dụng sợi nấm, kết hợp với nước sốt bọt làm từ nấm và một ít giấm táo balsamic đặc. Thực khách rất thích món ăn này.
Thách thức lớn nhất đối với nhóm nghiên cứu là đảm bảo sản xuất đồng đều và có thể mở rộng quy mô. Kết cấu, dinh dưỡng và độ an toàn là những lĩnh vực quan tâm chính của nhóm nghiên cứu trong phòng thí nghiệm chuyên sản xuất thực phẩm thay thế từ nấm.
Hiện các nhà nghiên cứu đang sử dụng các công nghệ như máy phân tích kết cấu để nén mẫu và đo độ bền. Chiếc máy này tạo ra những đường gợn sóng trên màn hình thể hiện độ bền và độ đàn hồi của nấm, những đặc điểm quan trọng khi thiết kế các sản phẩm thực phẩm gần giống với cảm giác khi ăn thịt hoặc hải sản.

























